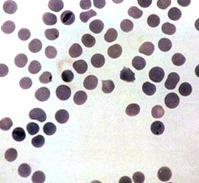

|
Tick Borne Diseases
|
Identification of Ticks
Introduction
The occurrence of ticks in Africa is one of the major limiting factors to livestock productivity. Ticks not only sucks blood thereby generally weakening their hosts if they are many enough - they also act as major disease carriers between various species of animals. There are over 13 different tick families and more than 650 different kinds of ticks in Africa. All of them suck blood and when occurring in numbers can actually kill especially young livestock by sucking alone.
In this section we only mention the most economically important species of ticks - the ones that have been identified as major carriers of the diseases mentioned in the articles below.
In this section we only mention the most economically important species of ticks - the ones that have been identified as major carriers of the diseases mentioned in the articles below.
Families of Ticks:
The main families of ticks that affect livestock in East Africa are:
1. Soft Ticks (Argas and Ornithodoros families
2. Hard Ticks (Rhipicephalus, Amblyomma, Hyalomma, Boophilus etc)
1. Soft Ticks (Argas and Ornithodoros families
2. Hard Ticks (Rhipicephalus, Amblyomma, Hyalomma, Boophilus etc)
Soft ticks
The soft ticks are a big problem for poultry and other small stock, but as far as literature has indicated do not seem to take a big part in transfer of diseases generally in livestock.
Soft ticks are usually fairly small (rarely above 5mm long). Their mouth parts are not easily seen as they sit on the underside of the tick, and their backs do not have the "Scutum" or hard back shield that the hard ticks have.
|
Soft tick
|
|
||||
|
Soft tick
|
|
Hard ticks
The main disease carriers are the following:
1. The Blue tick, or cattle tick (Boophilus sp) This major family have many species each of which have different geographical distribution. The blue tick is instrumental in transferring both Anaplasmosis and Babesiosis which are both major diseases of cattle in East Africa.(please see below).
2. The brown Ear tick (Rhipicephalus sp) is not always easy to distinguish from the blue tick, but whereas the blue tick can be found anywhere on the body, the brown ear tick prefers areas around the ears an under the tail. The brown ear tick is responsible for transferring East Coast Fever (ECF) in cattle and Nairobi Sheep disease. (Please see below)
3. Hyalomma ticks - often with striped legs, but no ornamentation on the back. It transfers Sweating sickness of calves/cattle (see below) and
4. Amblyomma ticks transfer Heartwater disease (see below). These ticks have striped legs, sometimes a distinct ornamentation on the back shield and can often be seen boring right into the skin of the animals, thereby becoming very difficult to remove by hand. Often fairly large ticks - more than 5 mm long.
2. The brown Ear tick (Rhipicephalus sp) is not always easy to distinguish from the blue tick, but whereas the blue tick can be found anywhere on the body, the brown ear tick prefers areas around the ears an under the tail. The brown ear tick is responsible for transferring East Coast Fever (ECF) in cattle and Nairobi Sheep disease. (Please see below)
3. Hyalomma ticks - often with striped legs, but no ornamentation on the back. It transfers Sweating sickness of calves/cattle (see below) and
4. Amblyomma ticks transfer Heartwater disease (see below). These ticks have striped legs, sometimes a distinct ornamentation on the back shield and can often be seen boring right into the skin of the animals, thereby becoming very difficult to remove by hand. Often fairly large ticks - more than 5 mm long.
|
The Blue tick
|
|
|||||
|
The Brown Ear tick
|
|
|||||
|
Amblyomma ticks
|
|
|||||
|
|
Anaplasmosis
Local names:
Embu: ndigania / Gabbra: biraa / Kamba: nthiana / Meru: nthiana / Kipsigis: cheptikonit / Gikuyu: ndigana / Maasai: Entorhobo, lipis, endigana, engemomywa oldigana oiboir / Samburu: mporot, ndiss / Somali: ndaratu, gabgab, jooge, racamo / Swahili:ndigana baridi / Turkana: lonyang', lopid / Nandi: kipkuit /
Embu: ndigania / Gabbra: biraa / Kamba: nthiana / Meru: nthiana / Kipsigis: cheptikonit / Gikuyu: ndigana / Maasai: Entorhobo, lipis, endigana, engemomywa oldigana oiboir / Samburu: mporot, ndiss / Somali: ndaratu, gabgab, jooge, racamo / Swahili:ndigana baridi / Turkana: lonyang', lopid / Nandi: kipkuit /
Common names:
gall sickness, anaplas, anaplasmose bovine (French)
gall sickness, anaplas, anaplasmose bovine (French)
Description:
Tick borne disease
Tick borne disease
Introduction
Anaplasmosis an acute (rapid onset and short but severe), fever producing disease of cattle, usually transmitted by Boophilus species Blue ticks and caused by a parasite which multiplies by binary fission in red blood cells, causing severe anaemia. Severe Anaplasmosis is caused by Anaplasma marginale. This parasite occurs at the edge of the red cells. A mild,usually inapparent form is caused by Anaplasma centrale. This parasite occurs at the centre of the red blood cell.
The incubation period of the disease is about 2 - 12 weeks and is directly related to the infective dose.
The disease occurs throughout the tropical and subtropical regions of the world
|
Mode of spread
Anaplasmosis is not contagious. The source of infection is always the blood of an infected animal.
Transmission does not take place by contact but generally via the medium such as the:
|
|
Infections in the sucking young usually does not happen . Once infected, animals remain carriers for life. In areas where cattle first become infected with Anaplasma marginale early in life, losses due to anaplasmosis are minimal. In animals less than 1 year old Anaplasmosis is usually subclinical, that is, there are no symptoms. in yearlings and 2-year-olds it is moderately severe, and in older cattle it is severe and often fatal.
Exposure of calves to infected ticks gives them an often life-long resistance. Paradoxically efficient tick control at this stage of their life will later expose cattle to possible life-threatening anaplasmosis. These facts must be kept in mind at all times.
Zebu cattle, with their relative resistance to heavy tick infestations, are less likely to be infected, but they are just as susceptible as European breeds. Carrier animals serve as reservoirs for further transmissions.
Serious losses can occur when mature cattle with no previous exposure are moved into areas where the disease is prevalent or when transmission rates are insufficient to ensure that all cattle are infected before reaching the more susceptible adult age. This latter situation can occur when a previously effective acaricide becomes ineffective, especially when it has previously been effective from calfhood into adulthood.
Clinical signs and diagnosis
Onset of illness is characterised by a:
- rising fever of up to 41 degrees Celsius (106 degrees Fahrenheit),
- drop in milk production, and
- decreased appetite. Severely affected animals lose condition rapidly and very severely affected animals may die within a few hours of the onset of symptoms.
- severely affected animals are depressed, lose their co-ordination and become breathless and lag behind the rest of the herd if exerted. If forced to walk some of these animals may even lie down. These symptoms are directly related to the degree of anaemia caused by the destruction of red blood cells.
- examination of the eyes and vulva will reveal a change from a healthy pink to a pale white to yellow, or even light orange colour. This indicates the onset of jaundice due to liver damage. The teats of a milking animal appear pale or white in colour.
- there is a rapid, pounding heart rate. This is easily heard by pressing one's ear against the animal's pelvis. This loud beat, heard several feet from the heart itself, is almost diagnostic for Anaplasmosis. It cannot be heard in a normal animal.
- the urine may be yellow or even brown, but, unlike Babesiosis (Redwater) contains no red blood cells.
- constipation is common.
- pregnant animals often abort.
- some animals are hyperexitable and aggressive, charging and attacking people.
- in the severe form of the disease, there may be death if immediate treatment is not given.
- in dead animals, blood is thin and watery and the flesh is pale yellow. The liver is yellowish orange. The gall bladder is large and full of brownish greenish fluid and the kidney is large and soft. The spleen is enlarged and mushy.
Diagnosis
A presumptive diagnosis can be made based on an assessment of the history, clinical and post mortem signs, together with the appearace of ticks and an anaemia without red blood cells in the urine. A peripheral blood smear from the ear should be taken for laboratory analysis by qualified personnel to confirm the disease.
Anaplasmosis is generally not such a severe disease as Babesiosis (Redwater), with which it might be confused. In Babesiosis the urine contains red blood cells, sometimes is almost black in colour and the individual death rate is usually much higher.
Prevention and recommended treatments
Prevention and control
- Regular dipping and spraying with effective solutions to control tick infestations are vital preventive measures. In non-East Coast Fever areas, and in most extensive systems, young calves are often not dipped for the first few months. This allows them to contract the disease and confers immunity.
- Eradication is generally not practicable due to the ubiquity of the carrier ticks, the long period of infectivity in carrier animals, the presence of carriers in the wild animal population and the difficulty of identifying infected animals.
- Vaccines are available and used in some countries. These are either livng attenuated strains of A. Marginale coupled with treatment if required, or the less pathogenic A.Centrale. Severe reactions can occur with both types of vaccine.
Recommended treatment
- The drugs of choice for treatment are tetracyclines and Imizol (midocarb dipropionate)
- Oxytetracycline long-acting solution is effective given early in the disease at a rate of 30mg per kg i/m. Likewise imidocarb at 3mg/kg. These dosages will not elimiate the carrier state. For this repeated injections at a higher dose level are required, which may not be appropriate in Kenya at the present, due to the widespread abundance of the organism in recovered, immune animals.
- Constipated cattle should be given a dose of Epsom Salts - 500g (1lb) is a suitable dose for an adult animal. Also molasses drench is useful combined with plenty of drinking water. Careful nursing and provision of an appropriate diet with green feed will assist recovery. Avoid giving hay, dry straw and grains to constipated cattle.
Babesiosis
|
Local names:
Luo: aremo / Kiswahili: ugonjwa wa kukojoa damu / Turkana: eyiala, lopid, lobul / Nandi: sasioto / Kipsigis: beek che biriren / Gikuyu: munyuria / Maasai: enado nkulak, ol odulak / Meru: maumago yamatune / Samburu: nkula, ngula / Borana: dukub shilmil / Pokot: Kipirir, pkison
Common names:
Piroplasmosis, red water, tick fever, Texas fever, La tristeza, piroplasmose bovine (French), Fiebre del texas (Spanish)
Description:
Tick borne disease |
|
|
Introduction
Babesiosis or Redwater is a very severe disease, considerably more so than Anaplasmosis.This is a fever producing disease of cattle, caused in Africa by the protozoan parasites Babesia bigemina and Babesia bovis. The disease occurs worldwide but has serious implications in the tropics because of the high prevalence of the host ticks. Other names of this disease are Red water and Cattle tick fever.
Mode of spread
Babesiosis parasites are spread only through their carrier tick. Ticks acquire babesia infections from infected animals.
In Africa, the Cattle tick which transmits B. bovis was introduced at the end of the 19th century. B.bovis thus only occurs in those areas of Africa to which Cattle tick has spread. In Kenya the Blue tick, Boophilus decoloratus, which is the main transmitter, can only transmit B. Bigemina and as a result this species assumes more importance than B. bovis.
Tranmission occurs transovarially, that is, from the maternal body to eggs within the ovaries. In areas where Babesiosis occurs,two features are important in determining the risk of the disease occuring.
1) Calves have a degree of immunity (related both to colostral-derived antibodies and to age) that persists for about 6 months.
2) Animals that recover from Babesia infections are generally immune for life.
2) Animals that recover from Babesia infections are generally immune for life.
Thus, where there are high levels of tick infestation, all newborn calves will be infected by Babesia parasites by 6 months of age. On recovery from initial infection they are immune but harbour the parasite (premune) and may remain carriers for up to 2 years. In areas where Babesiosis is prevalent, constant reinfection ensures that such cattle remain carriers permanently, although the premunity may break down due to other factors such as stress or other diseases occuring at the same time, resulting in clinical babesiosis.
This stability can be upset by either natural factors such as seasonal variation or artificial factors such as drought, dipping etc. Reduction in tick numbers to levels such that tick transmission of Babesia to calves is insufficient to ensure all are infected during this early critial period. In this case some animals remain at risk. If these are infected as adults, they may suffer severe clinical reactions.
Thus in enzootic areas:
1) Enzootic stablity:- The continuous presence of Babesia in both cattle and ticks with frequent acquisition of the parasite from active infective ticks ensures that cattle are infected in calfhood and remain carriers due to contant reinfection.Under these conditions clinical babesiosis is minimal.
2) Enzootic instability:-The infection of Babesia is such that not all cattle are infected as calves, and therefore some animals remain susceptible. If these are infected as adults, they may suffer severe clinical reactions. Such conditions arise when the number of ticks fluctuate due to factors such as seasonal variation, drought, dipping etc.
The incubation period ( the time from tick attachment to the appearance of parasites in the red blood cells) is normally in the range of:
- 8-16 days for B.bovis as transmission occurs early larval stages of ticks
- at least 9 days longer for B.bigemnia because infection is not transmitted until the nymph and adult stages of the tick begin to feed.
Ticks acquire babesia infection from infected animals.
Signs of Babesiosis
Signs
Babesiosis or Redwater is a very severe disease often confused with but more severe than Anaplasmosis.The first indication that the disease is present may be finding of a dead animal - usually an adult - in the paddock.
The parasites invades the red blood cells where they multiply and break out to invade more red blood cells. The released parasite and host constituents from the destroyed red cells are toxic, resulting in shock, anaemia and short supply of oxygen to tissue.
- Blood in urine: The release of haemoglobin results in jaundice and blood in the urine. The urine is usually, but not always, red in colour. Sometimes the urine is dark red and sometimes it can be almost black. Such animals are very ill indeed and usually die.
- High temperature: There is a rise in temperature. This is often 41 degrees Celsius (106 degrees Fahrenheit) or higher.
- Affected animals become depressed, listless, rumination ceases, milk yield drops, and they refuse to eat.
- Pregnant animals often abort
- Pale eyes and gums: The eyes and gums are pale from anaemia and jaundiced (yellowish), due to bile pigments in the blood stream.
- In severe cases, brain capillaries become blocked with infected red blood cells causing cererbal babesiosis resulting in incoordination followed by posterior paralysis,or by mania,convulsions and coma. Such animals rarely recover, despite treatment.
- In less severe cases of the disease, infected cattle have fever lasting about 1 week and remain sick for 3 weeks. This group of animals may recover slowly while pregnant animals may abort. Recovered animals remain permanent carriers of the disease. Zebu cattle appear to have more resistance to babesiosis than do European breeds.
- Post mortem fndings reveal an enlarged spleen, a swollen liver, with an enlarged gall bladder containing dark green granular bile, congested dark-coloured kidneys, and generalised anaemia and jaundice. The urine is usually, but not always, red in color.
Diagnosis
The diagnosis can be confirmed in a laboratory by the examination of a stained blood smear taken from the ear or tail tip. A number of serological tests are available but generally these are out of reach under local conditions.
Under the microscope B. bigemina parasites are large organisms, seen within the red cells in pairs at an acute angle to each other. B. bovis are small and lie at an obtuse angle to each other.
A number of serological tests are available such as the indirect fluorescent antibody test, ELISA and the complement fixation test, but generally these are out of reach under local conditions.
Other diseases must be considered when an animal is seen to be passing red urine. Possibly the most important of these is:
- Leptospirosis. This disease also presents with red urine, jaundice, abortion, depression and loss of appetite. However there are no blood cells in the urine, it affects all ages, including young calves and the degree of jaundice is often more profound due to the more chronic nature of the disease. Sensitivity to light of white skin is common. Leptospirosis often occurs during periods of heavy rain as rodents frequently are carriers, passing the infection in their urine, which can then survive for extended periods of time in pools of water.
- Heartwater may also initially be confused with cerebral babesiosis but there are clinical differences and no babesia parasites will be found in stained smears.
- Anaplasmosis is a less severe disease with no blood cells in the urine.
Prevention - Control - Treatment
Prevention and Control
At the moment in Kenya prevention must rely on tick control and trying to reach a situation of enzootic stablity by aiming to control the ticks but not the disesase they transmit so that young stock are infected and develop a lifelong immunity. This can be difficult in areas where other ticks transmitting other diseases such as East Coast Fever occur. The Blue tick is normally the first tick to develop resistance to new acaricides. The results of this resistance can be dangerous.
It is advisable to keep suitable breeds of animals in areas where the disease is prevalent. Such breeds may include indigenous cattle and their crosses with exotic cattle. With these breeds the dipping or spraying intervals can be extended as these local breeds have more resistance to babesiosis and also to ticks, but with European breeds, tick protection is required.
The whole picture must be considered before taking any decision regarding extension or reduction of dipping or spraying intervals.
Vaccination using live, attenuated strains of the parasite has been used successfully in a number of countries. Combined vaccinaton and strict control of ticks is an effective control strategy when exotic cattle are introduced. Young animals can be vaccinated with live vaccines to counter periods of inactivity of ticks. These techniques are currently unavailable in Kenya so a carefully monitored tick control program is required to allow the development of resistance in conjunction with the control of other tick-borne infections.
Recommended treatment
Two drugs are currently available for the treatment of Babesiois. These are:
- Diminazene aceturate (Norotryp, Berenil etc) and
- Imidocarb dipropionate ( Imizol).
Dimiazene is given at a dose rate of 2 to 5mg/kg by intramuscular injection.
Imidocarb is given at a rate of 1.2mg/kg by subcutaneous injection.
Higher doses of both drugs will protect animals for several weeks.
Large species of Babesia such as Bigemina are more responsive to treatment than the small species such as Bovis which may require a larger dose of the same drug to effect a cure. Fortunately Bigemina is the more common species in Kenya.
The aim of treatment is to promote recovery from the clinical disease while allowing some organisms to persist in order to allow the animal to develop an immunity to the disease. Too rapid a cure can result in the animal being susceptible to reinfection.Thus, treatment which immediately sterilizes the infection should, if possible,be avoided. This can be difficult when faced with severe cases when delayed treatment means death of the animal. In such cases, preventive treatment of the rest of herd should be considered.
Supportive treatment is advisable. This may include the use of non-steroidal anti-inflammatory drugs, multivitamins, fluid replacement and in some cases, blood transfusions.
Bovine Petechial Fever
Common names:
Ondiri disease
Description:
Tick borne cattle disease
Introduction
Bovine Petechial Fever is a cattle disease, characterised by haemorrhages, fever, oedema, and abortion in pregnant animals. The cause is an organism called Ehrlichia ondiri because the disease was first identified at Ondiri, near Kikuyu, on the outskirts of Nairobi. To date the disease has only been confirmed in the highlands of Kenya at altitudes of over 1500m (5000 feet), although it is considered likely to occur in neighbouring countries with a similar geographical features. Suspected cases have occurred in the isolated highlands of eastern Tanzania.
Mode of spread
It is not known how the disease is transmitted, but a tick of restricted distribution is suspected.
The organism is believed to be endemic in wild ruminants, particularly reedbuck and bushbuck, and it sporadically spills over into domestic cattle grazing in or at the edge of forest or scrub where these animals live. The disease is restricted to scrub or forest edges which have heavy shade, a thick layer and a high relative humidity.
It occurs sporadically throughout the year in exotic cattle. Indigenous cattle appear to undergo infections that are not visible. Bushbuck and indigenous local cattle are proven natural hosts.
Signs of Bovine Petechial Fever
Illness has not been reported in the true natural host, the bushbuck. The incubation period in cattle following natural exposure is believed to be 5 to 14 days.
Reactions in recently imported cattle are very severe. They include:
- Sudden high fever
- Abrupt drop of milk yield
- Numerous petechiae (small red spots caused by bleeding from broken capillary blood vessels) on the mucous membranes of the eye, the inside of the vulva, and the lower surface of the tongue
- Fluid accumulation in the lungs (Pulmonary oedema)
- Death within 3 days.
The severe form of the disease lasts longer. Signs include:
- A fluctuating fever
- Drop in milk yield
- Dullness in affected animals
- Pregnant cows abort, most likely due to the high fever.
- 24 - 72 hours after the onset of fever petechiae are seen, which fade within hours to be replaced by fresh petechiae, the cycles continuing for 7 -10 days.
- Often the nasal discharges are blood-stained and the dung is black, tarry and blood-stained.
- Sometimes one eye protrudes, the conjunctivae (the mucous membrane that lines the inner surface of the eyelid and the exposed surface of the eyeball) are swollen, the eyelids are turned outward, the eyeball is tense and the aqueous humor (the clear, watery fluid that fills the chamber of the eye between the cornea and the lens) is displaced by blood. This is the so-called poached egg eye.
- Up to 50% of affected animals will die.
Less severe infections show few signs apart from loss of condition and anaemia.
Diagnosis
The history, clinical signs, geographic location and post mortem finding should assist reaching a diagnosis. Post-mortem will reveal the presence of widespread ruptured blood vessels and oedema (accumulation of excessive amount of fluid). Haemorrhages are usually very marked in the mucosa of the urinary bladder and throughout the length of the alimentary tract and in the heart. The carcase is usually in good condition. Lymph nodes are usually enlarged. The spleen may or may not be enlarged.
For full confirmation a veterinarian will examine a blood or spleen smear to detect the organism Ehrlichia ondiri.
The disease must be differentiated from other haemorrhagic diseases such as Rift Valley Fever, Haemorrhagic Trypanasoma vivax infections, acute ECF, Heartwater, bracken poisoning, and Haemorrhagic Septicaemia. Hence the need when symptoms first occur to seek the assistance of a veterinarian.
Prevention - Control - Treatment
Prevention and control
- Separate cattle from areas frequented by bushbuck and reedbuck
- Keep cattle away from forest edges
- Isolate any animal showing sudden fever with a drop in milk yield
- Examination of blood smears by a qualified veterinarian
In recent years, incidences of Bovine Petechial Fever have declined because extensive development of farmland has cleared and eliminated bushbuck and reedbuck habitat.
Treatment
Tetracyclines are the drugs of choice. Double doses are required in the presence of symptoms. If given during the incubation period normal doses are enough.
Most recovered animals become carriers and relapses may occur. Resistance to re-infection continues for up to 2 years following recovery.
East Coast Fever Complex (Theileria parva parva, Theileria parva lawrencii)
Local names:
Gikuyu: ngai / Kamba: ngai / Embu: ngai / Gabbra: shilmi dimtu / Maasai: oltikana, oldigana / Kipsigis: sosoito / Swahili: ndigana / Turkana: lokit, loleeo, lipis / Iteso: angaarwei / Luidakho: yapwolo / Luvugusu: gamavumba / Nandi: cheptigonit / Pokot: cheptikon, lipis / Maragoli: ivitu, evivitu / Meru: ita / Samburu: lipis / Borana: lipis / Somalia: udhurshillin kener
Gikuyu: ngai / Kamba: ngai / Embu: ngai / Gabbra: shilmi dimtu / Maasai: oltikana, oldigana / Kipsigis: sosoito / Swahili: ndigana / Turkana: lokit, loleeo, lipis / Iteso: angaarwei / Luidakho: yapwolo / Luvugusu: gamavumba / Nandi: cheptigonit / Pokot: cheptikon, lipis / Maragoli: ivitu, evivitu / Meru: ita / Samburu: lipis / Borana: lipis / Somalia: udhurshillin kener
Common names:
Theileriosis, African coast fever, la fievre de la cote orientale (French), fiebre de la costa oriental Africana (Spanish)
Theileriosis, African coast fever, la fievre de la cote orientale (French), fiebre de la costa oriental Africana (Spanish)
Description:
Tick borne protozoal parasite disease
Tick borne protozoal parasite disease
Introduction
East Coat Fever is a non-contagious fever-producing disease of cattle transmitted by the brown ear tick.
"Classical" East Coast Fever is caused by a protozoal parasite closely related to Babesia called Theileria parva parva, which invades the lymph nodes. It is transmitted by brown ear ticks (Rhipicephalus appendiculatus) and characterised by high fever, an abnormal lowering of the white blood cell count and severe damage to the lymphoid system. The disease is localised to East and Central Africa - Kenya, Uganda, Tanzania, Rwanda, Burundi and Malawi with extensions into the Congo, Zambia, Southern Sudan and Mozambique.
Corridor Disease is caused by Theileria parva lawrencii and is transmitted from buffalo to cattle by Rhipicephalus appendiculatus in Eastern Africa and also by Rhipicephalus zambezienis in the low veldt of Central Africa. It is called "Corridor" Disease as it was first discovered in a corridor of land between the Umfolozi and Hluhluwee Game Reserves in Natal in South Africa. When the disease appears in areas where there is chance of close contact between buffalo and cattle, usually at forest edges, on uncleared land or in areas of dense bush, cattle keepers should expect occurrence of corridor disease.
Other less infectious forms of the disease are widespread in tropical and subtropical regions of Africa, Asia and southern Europe. These include T.parva bovis, mutans and taurotragi.
Mode of spread
"Classic" East Coast Fever is transmitted from cattle to cattle by the Brown Ear Tick, Rhipicepahalus appendiculatus. The distribution of East Coast Fever is geographically confined by the distribution of the Brown Ear Tick and by whether the tick can undergo more than one life-cycle per year. This confines it to areas of rainfall of more than 750mm per year and where it is not too cold or high. There are large areas of Africa where the tick is present but not the disease. There are no areas where the disease is present but not the tick.
Corridor Disease is not normally maintained in cattle. Close contact is required between buffalo and cattle, usually at forest edges, on uncleared land or in areas of dense bush.
Incubation varies between 9 to 18 days, most commonly 14 to 16 days after exposure to infective ticks.
Parasites in the blood of an infected animal are picked up by immature stages of the tick. These complete feeding, drop off and moult and then, at the next stage in their life stage, attempt to feed. If picked up by a susceptible animal, the parasites in their salivary glands complete their development over the 3 days after attaching and, between the third and fifth day of feeding, the tick secretes infective sporozoites into the new host.
One tick will transmit sufficient sporozoites to kill a susceptible cow. Both European and local breeds from areas where the disease is not endemic are susceptible but Zebu cattle are more resistant. This, coupled with their relative resistance to ticks, makes them significantly more resistant to East Coast Fever than European breeds. However, Zebu cattle from areas where there is no East Coast Fever are equally susceptible to infection.
Infected ticks may live for 1 - 2 years but normally they lose the infection in about 11 months. Infected and clean ticks do not move, although they may be carried by animals or man. If cases occur on a farm it must be remembered that further cases may occur during the next year. A close watch must be kept at all times. There is no room for relaxation of standards.
Clinically infected cattle, exhibiting the parasites, are the chief source of infection for the tick. In classical East Coast Fever cattle do not remain as carriers but exceptions are now reported with increasing frequency and effective disease control programs have been based on this premise.
In East Coast Fever enzootic (prevalent) areas a high proportion of cattle naturally acquire immunity to the disease when first exposed as young calves of immune dams. This immunity effectively protects them against an otherwise lethal challenge. This, however, will not occur in non-enzootic (non-prevalent) areas.
Signs of East Coast Fever
Signs
- The parotid lymph nodes below the ear become enlarged 14 to 16 days after attachment of the tick.
- A few days later a fever develops. This can be up to 41 degrees Celsius to 42 degrees Celsius (106 degrees Fahrenheit to 107 degrees Fahrenheit).
- Milk yield decreases
- Other superficial lymph nodes enlarge, especially those in front of the shoulder joint and in front of the stifle joint of the hind leg. These are often clearly visible to the attentive observer.
- Appetite decreases, body condition declines, parasaties appear in the blood and the animal is infective to ticks and hence to other animals
- There is fluid in the lungs and pneumonia occurs. The animal breathes increasingly rapidly and with increasing distress. It starts to cough, especially if made to move and nasal discharge is common.
- The eyes often appear milky or blue and there may be shedding of tears.
- Sometimes there is diarrhoea which can be violent or blood stained.
- There is muscle wasting and posterior weakness
- Finally the animal collapses and dies, usually about 18 to 26 days after tick attachment.
Diagnosis
Very often when an animal has died from East Coast Fever or Corridor Disease there is a pile of white froth lying on the ground in front of its nostrils. The sight of this should always stir an observant person into thinking about ECF/Corridor Disease. This froth is due to the massive pulmonary oedema (lung fluid) which has killed the animal.
Post mortem examination will reveal lungs full of fluid and the windpipe full of white froth. Cutting the lungs with a knife will release a flood of fluid from the now clearly defined pulmonary lobules. This is a dramatic, almost diagnostic sign.
Lymph nodes are enlarged and fluid-filled. The kidneys may have white spots on their surface - "infarcts". In the abomasum or fourth stomach may be seen punched out erosions.
A final diagnosis is dependent on identifying the parasite in the animal. Blood smear and gland (biopsy) smears should be taken for laboratory analysis by a qualified vet to confirm the disease.
The overall picture should be taken into consideration. A change in some aspect of management some 2 to 3 weeks earlier, a change of acaricide (tick-killing solution), the appearance of ticks, increased rainfall or improved ground cover leading to extended tick survival, the intrusion of buffalo, illegal cattle movement within the area, all must be considered when formulating a strategy for control.
Apart from the clinical picture, post mortem findings and the examination of blood and lymph node smears there are a number of serological diagnostic tests, but these are of limited value in the field.
Diseases with similar symptoms
Enlarged lymph nodes, coughing, watery eyes and discharge from the nose: See Trypanasomiasis and Malignant Catarrhal Fever.
Prevention - Treatment - Control
Prevention/Control
- The infection and treatment method of immunisation against East Coast Fever is gaining ground. The antibiotic used is a long acting (LA) Oxytetracycline, which inhibits development of the parasite when given at the onset of infection. The animal is injected with live vaccines of East Coast Fever. This will confer protection to this strain for more than 3 years. However there are different strains of East Coast Fever and when immunised cattle are moved to a different area they may not be protected. Likewise if infected cattle from another area move in to a property they may bring in with them other strains of East Coast Fever.
- Effective Tick control. Tick control continues to be the most important measure in the fight to prevent cattle from becoming infected with East Coast Fever. The Brown Ear Tick is a three host tick i.e. it does not spend its entire life on the animal but drops off between the various stages of its life cycle; therefore when an outbreak occurs, either on the property or in the immediate area, once weekly dipping or spraying will not be sufficient. Dipping or spraying must be done twice weekly to break the transmission cycle between cattle and tick and continued as long as is necessary, for example if the tick problem continues to be unacceptably high. Pyrethrum grease should be applied to the inside of the ears and below the base of the tail, whose end should be clipped. All of this is costly, but not as costly as losing valuable stock or having to use very expensive curative drugs.
- Newer tick control measures include the Spot-on / Pour-on drugs
Treatment
Treatment of East Coast Fever / Corridor Disease is effective but it MUST be started EARLY in the disease process by a qualified veterinarian. Once the disease is well established treatment may not be effective. Available curative drugs are very expensive so every effort must be made to prevent infection from becoming established in the first place.
The drugs available for treatment are Parvaquone ("Clexon"), Buparvaquone ("Butalex" and others) and Halofuginone ("Terit"). The first two are given by intramuscular injection, the last by mouth. The dose for Paravaquone is 20 mg/kg bodyweight, Buparvaquone 5mg/kg bodyweight and Halofuginone 1 mg/kg bodyweight. If there is no satisfactory response to treatment after 48 hours this treatment should be repeated. Together with one of these drugs the affected animal should be given Oxytetracycline by intramuscular injection, preferably a long-acting formulation to lessen the number of times the animal is handled and to lessen the number of injections given. A dose of 30mg/kg bodyweight should be given and under-dosage should be avoided. Most people tend to underestimate body weights. This must be avoided, both to ensure that the animal is given the correct dose and to avoid causing drug resistance.
Heartwater
Local names:
Samburu: ilmilo, sirgo / Rendile: sirgo / Borana: sirgo / Turkana: eidid, amili / Gabra:sirgo, qanno ree / Somali: gidhir, madhahta / Pokot: chemlei, chepripremot
Samburu: ilmilo, sirgo / Rendile: sirgo / Borana: sirgo / Turkana: eidid, amili / Gabra:sirgo, qanno ree / Somali: gidhir, madhahta / Pokot: chemlei, chepripremot
Common names:
cowdriosis
Description:
Tick borne
Introduction
Hearwater is an infectious, non-contagious disease of ruminants, including some antelope species. It occurs in areas infested by Amblyomma ticks. These areas include Africa south of the equator, island countries off the east coast of Africa, including Madagascar, and some islands in the West Indies. Some animals may show no symptoms once infected and act as carriers. Indigenous African cattle breeds appear to be more resistant than European breeds.
Heratwater is caused by an organism formerly called Cowdria ruminantium, which has now been re-named Ehrlichia ruminantium.
Mode of spread
The Amblyomma ticks that spread Heartwater require a warm and relatively humid climate and bushy grass country for their development. Therefore the disease occurs in the rainy season.
Every year this disease destroys the calf and lamb crops of nomadic stockmen after their herds and flocks are moved from arid tick-free areas where lambing and calving has taken place, to tick-infested dry-season grazing.
Indigenous animals, both wild and domestic, living in the presence of infected Ambylomma ticks, often do not show symptoms when infected. Animals introduced from Heartwater-free areas, however, react severely.
Calves under 3 weeks, and lambs under 1 week, possess a high innate resistance.
Some small mammals and ground birds, such as guinea-fowl , and reptiles such as leopard tortoises, may play a part in the maintenance of infection, by carrying Amblyomma ticks and by being hosts to Ehrlichia ruminantium.
Signs of Heartwater
Clinical Findings
The incubation period following exposure to infected ticks ranges from 7 to 28 days. Clinical reactions in the very young are mild and are often not observed. Reactions in older animals are acute. The course of the peracute disease is measured in hours, that of the acute in 3-6 days
- There is a sudden onset of fever, which remains high until shortly before death.
- In peracute cases, animals develop fever, excessive watering from the eyes, and convulsions.
- In the acute form, there is loss of appetite, fever, and signs of central nervous system disturbance.
- Affected animals chew constantly, lick their lips, and flick their eyelids while circling with a high-stepping gait, or standing with legs straddled and head lowered.
- Nervous signs worsen, until the stricken animals subside into sternal recumbency and then into lateral recumbency and die during a galloping convulsion.
- Diarrhoea is sometimes seen.
![]() |
| Heartwater: Lateral recumbancy with extended legs |
| © USDA |
Diagnosis
Diagnosis is based on:
- Movement of susceptible animals into a known Amblyomma infested area
- Clinical signs and
- Post mortem findings
- The organism targets and damages the walls of the blood vessels
- Increased vascular permeability results in fluid effusion into tissues and body cavities resulting in a fall in arterial pressure and general circulatory failure.
- In peracute and acute cases there is oedema of the lungs and brain, collection of fluid in the chest cavity, within the pericardial sac (hence the name Heartwater) and in the abdominal cavity.
- There is enlargement of the spleen, engorgement of the liver and occasionally haemorrhagic gastro-enteritis.
The brain oedema is responsible for the nervous signs so often observed. In order for a final diagnosis to be reached a veterinarian must be on hand to take brain crush smears to examine stained capillary endothelial cells for the dark purple colonies of Ehrlichia ruminantium.
Diseases with similar symptoms
- Cases in which there is sudden death must be differentiated from Anthrax and acute ECF, Plant poisoning and acute Redwater (Babesiosis).
- Nervous cases should be differentiated from tetanus, Rabies, Cerebral Anaplasmosis, Cerebral ECF and Strychnine poisoning used in baiting of dogs.
Prevention - Control - Treatment
Prevention and control
A carrier state persists for several weeks following recovery. Resistance persists for longer - from 6 months to 4 years. Reinfection can occur but is usually clinically inapparent although subacute signs can occasionally occur.
- Dipping or spraying with acaricides at weekly intervals will reduce the incidence of the disease.
- Preventing the introduction of Amblyomma infested stock or fodder into clean areas. The excessive reduction of tick numbers, however, interferes with the maintenance of adequate immunity through regular field challenge in endemic areas and may result in heavy losses.
- There is as yet no widely effective and safe vaccine against Heartwater. However, an "infection and treatment" method with infected sheep blood or a suspension of infected nymphal ticks is used. This is injected iv (intravenous) and severe post-immunisation reactions are controlled by the administration of tetracyclines at the onset of fever, and then every 12 hours until the fever decreases.
In areas where the disease is endemic adult animals are normally immune and hence it is usually only necessary to immunise the annual calf of lamb crop. Animals derived from Heartwater free areas should be immunised.
Treatment
To be effective treatment must be carried out in the early stages of the disease.
- Oxytetracycline at 10mg/kg or doxycycline at 2mg/kg are usually effective.
- In sheep, goats and susceptible cattle breeds, a higher dose (10-20mg/kg) of oxytetracycline may be required, especially if treatment begins late during the feverish reaction or after other clinical signs appear. In such cases the first treatment should be given intra veinously.
- A second and third treatment may be required before the fever abates, or a second injection intra muscularly with a long-acting oxytetracycline formulation may be given.
- In animals showing nervous signs diuretics and non-steroidal anti-inflammatory drugs are indicated.
Nairobi Sheep Disease
Introduction
Nairobi Sheep disease is a tick-borne viral disease, causing a haemorrhagic (bloody) gastro-enteritis (stomach infection) with high fever, pulmonary oedema (swellings of the lung), abortion and high mortality.
It occurs in Eastern Africa from Ethiopia , Somalia , through Kenya , Uganda and Tanzania , to Mozambique , Botswana and the Congo.
Mortality in susceptible sheep may reach 90%.
The causal nairovirus, of the family Bunyaviridae, is probably the most pathogenic virus known for sheep and goats. It is identical to, or closely related to, Ganjam virus, a tick-borne infection of sheep, goats and people in India; and is serologically related to Dugbe virus, another tick-borne infection occurring in cattle in West Africa, and to Crimean-Congo Haemorrhagic Fever virus of man. Man may be infected by all of these viruses, and with the exception of Crimean-Congo Haemorrhagic Fever, which causes a severe haemorrhagic disease in man, the symptoms are those of a mild febrile illness, characterized by generalized abdominal pain, headache and backache.
Modes of Spread
The principal tick vector is the Brown Ear Tick, Rhipicephalus apendiculatus.
The virus cycles silently between indigenous sheep and goats and rhipicephalic ticks. Clinical disease occurs when sheep and goats reared in tick-free areas are moved into tick-infested areas, or when sheep and goats from tick-infested areas enter tick-free areas while still harbouring infected ticks, which in turn feed on and infect susceptible sheep and goats.
Inapparent natural infections also occur in antelopes, and there is some evidence that the peri-domestic rat of East Africa is also naturally infected. Cattle appear to be refractory.
Although the antibody prevalence in man is high in Eastern and Southern Africa , clinical symptoms rarely occur.
The virus can survive for at least 18 months in unfed ticks. This means that eradication is very difficult. The virus may be transmitted trans-ovarially or trans-stadially. Other tick species, such as Amblyomma may also be responsible for transmitting the disease. Although the virus is shed in urine and faeces, the disease is NOT spread by contact.
Inapparent natural infections also occur in antelopes, and there is some evidence that the peri-domestic rat of East Africa is also naturally infected. Cattle appear to be refractory.
Although the antibody prevalence in man is high in Eastern and Southern Africa , clinical symptoms rarely occur.
The virus can survive for at least 18 months in unfed ticks. This means that eradication is very difficult. The virus may be transmitted trans-ovarially or trans-stadially. Other tick species, such as Amblyomma may also be responsible for transmitting the disease. Although the virus is shed in urine and faeces, the disease is NOT spread by contact.
Signs of Nairobi Sheep Disease
The incubation period is about 4-5 days, followed by a fever lasting for 1-3 days.
Illness is manifested by depression, lack of appetite, a slimy pus like, blood-stained discharge from the nose and a foul smelling dysentery causing painful straining. Pregnant animals frequently abort. Some animals may die within 3 days. In others the disease is prolonged for 5-9 days.
Clinical signs in animals reared in areas infested with infected ticks are usually not observed. In contrast the clinical response in susceptible sheep is per-acute, and mortality may reach 90%. The reactions in young lambs and kids are not as severe as in adults.
A natural attack gives survivors a life-long immunity with the production of antibodies.
Clinical signs in animals reared in areas infested with infected ticks are usually not observed. In contrast the clinical response in susceptible sheep is per-acute, and mortality may reach 90%. The reactions in young lambs and kids are not as severe as in adults.
A natural attack gives survivors a life-long immunity with the production of antibodies.
Diagnosis
Post-mortem reveals
- A severe bloody diarrhea and enlargement of all lymph nodes.
- In addition small haemorrhages (bruises) often stud the outside and inside of the heart.
- Skin haemorrhages have been seen in the fetuses of pregnant ewes which die.
- Haemorrhages have also been seen in several other organs, such as the caecum, colon, gallbladder and kidney.
- Conjunctivitis (eye infections) and dried crusts around the nostrils are also often seen.
The post-mortem signs, together with a history of movement of susceptible animals into a tick-infested area, should give rise to a presumptive diagnosis of Nairobi Sheep Disease.
Confirmation requires the detection of virus or viral antigen or antibodies. The preferred specimens are blood in anti-coagulant or serum from febrile animals, mesenteric lymph nodes and spleen, forwarded to the laboratory on wet ice. Various laboratory tests are available to confirm the diagnosis.
Similar diseases (diseases with similar signs)
- Peste des Petit Ruminants,
- Rift Valley Fever, Heartwater,
- Salmonellosis,
- Parasitic Gastro-enteritis and
- Coccidiosis.
Prevention - Control - Treatment
Treatment and Control
There is no specific treatment and any treatment is purely symptomatic.
Unaffected animals in a flock may be treated with acaricides to try to lessen infection by infected ticks.
Unaffected animals in a flock may be treated with acaricides to try to lessen infection by infected ticks.
In endemic areas infections with Nairobi Sheep Disease virus are silent and here infection does not warrant the application of control measures. However, sheep and goats imported into tick-infested areas should be vaccinated prophylactically before movement, or as soon as possible after they arrive.
Attenuated and inactivated vaccines are available, inactivated vaccines being the more effective
Attenuated and inactivated vaccines are available, inactivated vaccines being the more effective
Sweating Sickness
Introduction
Sweating sickness is a tick-borne, toxic condition that affects the skin and visible mucous membranes of cattle. The cause is a toxin attracted to skin, which is secreted by females of certain strains of the tick Hyalomma truncatum. Thus, it is not an infection. It is mainly a disease of young calves, although adults are also susceptible. It occurs in Eastern, Central and Southern Africa, and in Sri Lanka and India.
Mode of spread
The toxin develops in the tick, not in the calf. The potential to produce toxin is retained by ticks for up to 20 generations. The disease cannot be transmitted from an infected animal to a susceptible animal by contact or by inoculation of blood.
The severity of the disease depends on the length of time toxin-producing ticks spend on a susceptible animal. A very short period of time has no effect - the animal remains susceptible. A period just long enough to produce a reaction may confer immunity. But, if the exposure is longer than 5 days, severe clinical signs and death may result.
Recovery confers immunity which lasts for up to, and perhaps longer than 4 years.
Signs of Sweating Sickness
Clinical Signs
The severity of the disease ranges from the peracute (quick onset in the duration of a few hours only) to the inapparent, depending on how long the toxin-bearing tick has been attached. Clinical signs do not usually appear before ticks have been attached for about a week.
- Initial symptoms are fever, salivation, and reddening of the skin and visible mucous membranes.
- There is loss of appetite, watering of the eyes and nose, salivation, and tenderness of the skin.
- The skin feels hot and sometimes the eyelids stick together.
- A few days after the onset of fever a moist eczema appears. Sometimes this is generalised but more often it is localised to patches on the head, the neck, flank, axilla or groin.
- The hair is matted and sticks together with beads of watery fluid on the hair tips. Tufts of hair with skin attached can easily be pulled from these areas, exposing raw, red wounds.
- The skin is extremely sensitive and painful and has an unpleasant smell. The tips of the ears and the tail may slough.
- The coronets of the hooves sometimes become congested and very painful.
- The animal is distressed by bright sunlight and seeks shade. It resents being handled.
- It may have diarrhoea, nasal and oral erosions and a frothy nasal discharge. At this stage death may occur. If the animal does not die then the skin may become hard and cracked and predisposed to secondary infection or to fly maggot infestation.
Recovery is signalled by a resumption of appetite, but affected areas of skin remain thickened and corrugated. The hair is often shed from these areas- sometimes from the whole body- but regrows within 3-4 weeks.
Death in affected calves ranges from 30-70% and 100% of calves in areas where the disease is prevalent may be affected. This all depends on the numbers of ticks, the length of time they are on the host and the immune status of the herd.
Death in affected calves ranges from 30-70% and 100% of calves in areas where the disease is prevalent may be affected. This all depends on the numbers of ticks, the length of time they are on the host and the immune status of the herd.
Diagnosis
In its usual form, Sweating Sickness disease is easily recognized. Very severe cases may on the surface be confused with other acute conditions such as Anthrax, Redwater, Heartwater, and mineral and plant poisoning. But an acute moist dermatitis in calves in conjunction with the presence of Hyalomma ticks should aid diagnosis. The disease is not widespread and is localised to areas where Hyalomma ticks are present. The finding of these ticks is crucial to diagnosis.
Prevention - Control - Treatment
Prevention and control
A tick infestation of at least 3 days produces immunity. Eradication of the tick is rarely possible due to the fact that the larvae and nymphs can feed on alternative hosts. Dipping or spraying are the means of control.
Using an acaricide with a 2-3 day residual action at 7 day intervals will allow the ticks to feed for about 4 days, and so produce a mild or inapparent reaction with subsequent immunity. If the ticks are attached for less than 3 days, no immunity is developed and, if attached for more than 5 days there is the possibility of severe reactions and heavy mortality.
Treatment
There is no specific treatment, as this is not an infection. The best course is to remove the ticks, treat symptoms by good nursing, provide appetising foods, and administer antibiotics and sulphonamides to suppress secondary infections of the skin, respiratory and alimentary tracts.
Review Process
2. Hugh Cran , Practicing Veterinarian Nakuru. March - Oct 2010
3. Review workshop team. Nov 2 - 5, 2010
4. Addition of Nairobi Sheep Disease Oct 2011 by Dr Hugh Cran
- For Infonet: Anne, Dr Hugh Cran
- For KARI: Dr Mario Younan KARI/KASAL, William Ayako - Animal scientist, KARI Naivasha
- For DVS: Dr Josphat Muema - Dvo Isiolo, Dr Charity Nguyo - Kabete Extension Division, Mr Patrick Muthui - Senior Livestock Health Assistant Isiolo, Ms Emmah Njeri Njoroge - Senior Livestock Health Assistant Machakos
- Pastoralists: Dr Ezra Saitoti Kotonto - Private practitioner, Abdi Gollo H.O.D. Segera Ranch
- Farmers: Benson Chege Kuria and Francis Maina Gilgil and John Mutisya Machakos
- Language and format: Carol Gachiengo
Information Source Links
- Barber, J., Wood, D.J. (1976) Livestock management for East Africa: Edwar Arnold (Publishers) Ltd 25 Hill Street London WIX 8LL
- Blood, D.C., Radostits, O.M. and Henderson, J.A. (1983) Veterinary Medicine - A textbook of the Diseases of Cattle, Sheep, Goats and Horses. Sixth Edition - Bailliere Tindall London. ISBN: 0702012866
- Blowey, R.W. (1986). A Veterinary book for dairy farmers: Farming press limited Wharfedale road, Ipswich, Suffolk IPI 4LG
- Brightwell R, Kamanga J and Dransfield R (1998). Key Livestock Diseases of Dryland Kenya. Kenya Economic Pastoralist Development Association (KEPDA), P.O. Box 30776, Nairobi Kenya.
- Force, B. (1999). Where there is no Vet. CTA, Wageningen, The Netherlands. ISBN 978-0333-58899-4.
- Hall, H.T.B. (1985). Diseases and parasites of Livestock in the tropics. Second Edition. Longman
- Hunter, A. (1996). Animal health: General principles. Volume 1(Tropical Agriculturalist) - Macmillan Education Press. ISBN: 0333612027
- Hunter, A. (1996). Animal health: Specific Diseases. Volume 2(Tropical Agriculturalist) - Macmillan Education Press. ISBN:0-333-57360-9
- ITDG and IIRR (1996). Ethnoveterinary medicine in Kenya: A field manual of traditional animal health care practices. Intermediate Technology Development Group and International Institute of Rural Reconstruction, Nairobi, Kenya. ISBN 9966-9606-2-7.
- Merck Veterinary Manual 9th Edition
- Okello-Onen, J, Hassan S.M, Essuman S: Taxonomy of African Ticks, Reprint Jan 2006, ICIPE Scienc Press ISBN No: 92 9064 127 4
- Organic Farmer magazine No. 50 July 2009
- Pagot, J. (1992). Animal Production in the Tropics and Subtropics. MacMillan Education Limited London
- Sewell and Brocklesby. Handbook of Animal Diseases in the Tropics 4th Edition
- The Organic Farmer magazine No. 51 August 2009

Back